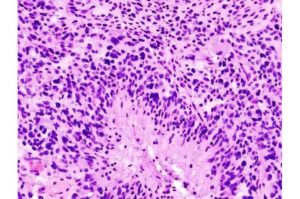

Aidoc Secures FDA Clearance for Healthcare’s First Comprehensive Foundation Model AI
11 newly cleared indications, combined with three existing ones, introduce an AI safety net for crowded Emergency Departments and imaging backlogs

11 newly cleared indications, combined with three existing ones, introduce an AI safety net for crowded Emergency Departments and imaging backlogs

BREA, Calif., Jan. 21, 2026 /PRNewswire/ — Rapid Nexus Nanotech Wound Solutions, Inc., a California-based medical technology company, today announced the publication of a peer-reviewed study documenting outcomes that challenge long-held assumptions about neuropathy-driven tissue damage and limb loss.

MFUSE is designed to support clinicians in managing external bleeding by forming a flexible hydrogel barrier when applied to the wound site

SurGenTec’s ION-C system is now indicated for the treatment of cervical pseudoarthrosis when implanted bilaterally within the facet joints.

The Xpert GI Panel identifies pathogens directly from stool specimens collected in Cary-Blair transport media.

mOm Incubators announced today that the FDA granted 510(k) clearance for its Essential Incubator system.

A new study shows that cancer damages its own DNA by pushing key genes to work too hard. Researchers found that the most powerful genetic “on switches” in cancer cells, called super-enhancers, drive unusually intense gene activity. That high gear creates stress on the DNA and can cause dangerous breaks.

A multidisciplinary team has developed a selective compound that inhibits an enzyme tied to inflammation in people at genetic risk for Alzheimer’s, while preserving normal brain function and crossing the blood-brain barrier.

What’s the first thing you did when you woke up this morning? Maybe you swung your legs over the side of your bed, placed your feet on the floor and stood up. Simple, right?
A team of Canadian scientists has uncovered a new way to slow the growth of glioblastoma, the most aggressive and currently incurable form of brain cancer—and identified an existing medication that could treat it.